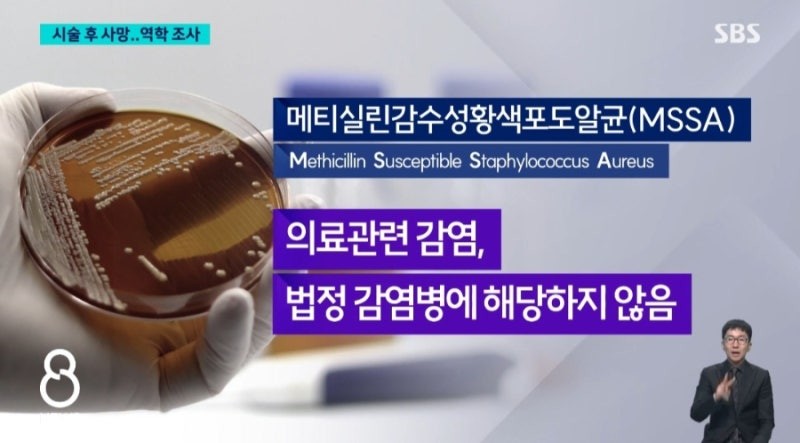

1. 국내 기업, 사원급 보다 부장급이 더 많다?
→ 30세 미만 직원보다 50대 이상이 더 많아.
기업분석연구소 리더스인덱스, 매출 500대 기업 조사.
지난해 기준 50세 이상은 20.1%로 30세 미만(19.8%)보다 많아.
두 연령대의 역전은 조사 시작(2015년) 이후 처음.(매경)

2. 아직도 1936년 베를린 올림픽 마라톤 우승자는 '기테이손'
→ IOC 홈페이지에는 손기정은 일본 국적,
이름은 손기정의 일본식 이름 '기테이손'으로 올라있어.
IOC는 우리 정부의 요청에 난색...
'식민지배를 받은 여러 국가 선수 국적을 모두 변경하는 것은 복잡한 문제',
'올림픽 개최 당시 역사적 상황을 반영해야 한다'는 입장.(세계)

◇ 손 기테이(일본어: 孫 基禎そん きてい)
3. 필리버스터가 소수당의 '최후의 저지선?
→ 현행 규정으로는 불가.
필리버스터 본래 취지는 무제한 토론을 이용, 다수당의 일방 진행이나 의결을 막는다는 것이지만 우리 국회법은 필리버스터 시작 24시간 후에는 재적 의원(298명) 5분의 3(179명)의 동의로 강제 종료 가능.
현재 범여권으로 분류되는 민주당(167명) 조국혁신당(12명), 진보당(4명) 의석은 183석으로 이 기준 넘어.(문화)

4. 강릉 한 의료기관에서 허리 통증 시술을 받은 환자 연이어 사망, 중태 등
→ 해당 의료기관에서 허리 신경 차단술 등 시술을 받은 환자 8명이 극심한 통증, 두통, 의식저하, 발열...
타 의료기관에서 입원치료.
이들 환자 중 1명은 사망, 2명은 중환자실, 3명은 일반 병실에 입원 중이고 2명은 퇴원했다.
보건당국은 사망자의 주된 사망 원인을 조사 중이다.(한국)

◇ 당국 MSSA 황색포도알균 검출 역학 조사 !
5. . 無니코틴 담배?, 알고보니 무니코틴이 아니었다
→ 無 니코틴으로 판매되는 액상 전자담배 다수에서 합성니코틴 검출.
현행 담배법상 '담배'는 연초 잎을 원료로 한 것만으로 규정돼 있어 합성니코틴으로 만들어지는 액상형 전자담배는 규제 대상(담배)가 아니라고.(문화)




6. 서울 세종문화회관 '누구나 클래식'
→ 시민들에게 수준급의 클래식 입문 프로그램을 제공하기 위해 개설된 프로그램.
해설도 있다.
관객들은 공연을 평가해 관람료를 1000원~1만원까지 자율로 낸다.
연주자들에겐 무료 공연의 안일함을 없애 질 높은 공연을 제공 한다는 취지.
매월 1회.(문화)


7. 귀지는 귀속에 그대로 두는 것이 좋다
→ 귓속 건강을 지키는 방어막이다.
외이도를 보호하고 박테리아의 증식을 억제하며, 약한 산성을 띠어 병원균의 번식을 막는다.
또한 항균 성분인 라이소자임을 함유해 스스로 균을 제거하는 능력도 있다.
또 수분을 흡수해 염증을 예방하고, 귓속 환경을 건강하게 유지하는 데 기여한다.
귀지는 자연스럽게 배출된다.
특별한 경우가 아니면 파낼 필요가 없다.(문화)


8. 대한항공, '프리미엄석' 도입
→ 일반석 요금의 110% 수준에 일반석보다 약 1.5배 넓은 좌석.
기내식도 프리미엄급으로 제공.
탑승 수속과 수하물 처리도 별도 서비스.
다음 달 중순부터 중·단거리 노선에 투입 예정.(아시아경제)


대한항공 '프리미엄석(Premium Class)' 좌석 예상 이미지 (사진 =대한항공)
◇세분화된 승객 수요 반영해 새로운 좌석 클래스 신설
◇한층 더 쾌적하고 고급스러운 고객 서비스 제공
9. 술 취해 경찰 때려도 실형 3.2%... 대부분 벌금 집행유예. 경찰 수난시대
→ 올해 전국 지방법원의 공무 집행방해 사건 중 주취자 키워드로 판결문 61건 분석.
실형은 징역 6개월, 징역 1년 2개월 등 2건 (3.2%)에 불과.
500만원 벌금형(30건 49.1%) 가장 많아.(아시아경제)


◇주취자 공무집행방해 판결문 분석
◇전과 누적·추가 범죄 시만 실형
10. 일, 쌀값 급등은 결국 생산 부족 결론... 쌀 감산 정책에서 증산으로 정책 전환
→ 지난해 주식용 쌀 수요가 711만으로 늘었지만 생산은 679만에 그쳐 32만가량 부족했다는 것.
2021년부터 따지면 생산량이 4년간 총 98만 부족했다는 진단.(한경)
출처 : 자전과 공전
'간추린뉴스' 카테고리의 다른 글
| 오늘의 날씨 🌞☔️☃️ , 2025년 8월 7일 목요일 (0) | 2025.08.06 |
|---|---|
| 오늘의 날씨 🌞☔️☃️ , 2025년 8월 6일 수요일 (0) | 2025.08.06 |
| 2025년 8월 6일 수요일, HeadlineNews (0) | 2025.08.06 |
| 간추린 뉴스, 2025년 8월 6일 수요일 (0) | 2025.08.06 |
| 2025년 8월 5일 화요일 , 신문을 통해서 알게 된 것들 (0) | 2025.08.05 |
